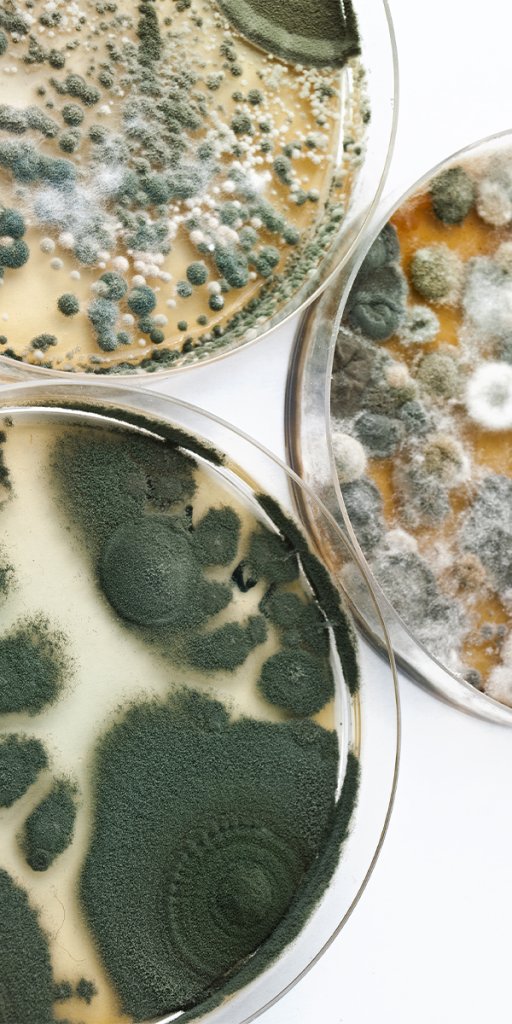

Acerca de Trace Analytics, LLC
Podemos adaptarnos a especificaciones de prueba como ISO 8573, ISO 14698, NFPA 1989, NFPA 99, OSHA, CGA, CSA, ISPE, USP y muchas más. Contáctenos para discutir sus necesidades de monitoreo ambiental y pruebas de aire comprimido.
LLAME GRATIS
1.800.247.1024
LÍNEA LOCAL
512.263.0000
HORARIO DE OFICINA (CT)
7:30 a. M. – 5:00 p. M.
30 años de experiencia
El laboratorio de Trace Analytics está acreditado por la Asociación Estadounidense de Acreditación de Laboratorios. Utilizamos equipos de laboratorio de última generación que nos permiten analizar cientos de muestras de aire comprimido diariamente con muy poca intervención humana.
Las pruebas de aire comprimido han sido nuestra especialidad desde 1989 – nuestro equipo de expertos de AirCheck✓™ tiene décadas de experiencia en el campo del análisis, las pruebas, la supervisión y la resolución de problemas del aire comprimido y del medio ambiente. Recibirá un servicio al cliente superior de manera rápida y amigable.
Prueba de aire respirable
Trace Analytics, LLC ha ofrecido a los clientes de aire respirable comprimido una forma asequible y precisa de probar el aire comprimido desde 1989.
Fabricación y pruebas ISO 8573
Más del 70% de las instalaciones de producción utilizan aire comprimido en el proceso de fabricación. La evaluación adecuada del sistema de aire comprimido y las pruebas periódicas pueden prevenir una contaminación grave y promover la salud general del sistema. Pruebe su aire comprimido según los requisitos de la norma ISO 8573 con Trace Analytics
¿No ve su industria?
Pruebas ambientales
CONVIÉRTETE EN DISTRIBUIDOR
Cuando te asocies con Trace Analytics, LLC convirtiéndote en Distribuidor de AirCheck✓™, te proporcionaremos la formación y las herramientas que necesitarás para realizar y vender pruebas de aire comprimido. Nuestro kit compacto AirCheck ✓ ™ es liviano y contiene varios recipientes de muestreo para probar los compresores de sus clientes. También le proporcionaremos una gran cantidad de suministros para que pueda cumplir con el cronograma y ahorrar en los costos de envío.
TESTIMONIOS
También me gustaría aprovechar este momento para agradecer a todos y cada uno de los miembros de Trace (incluso al Green Bay Packer Fan en el envío) por ser tan buenos socios comerciales. Su servicio al cliente es más que excelente. Todas y cada una de las veces que me he puesto en contacto con usted, sin importar con quién pueda hablar, siempre me atienden con un nivel de servicio al cliente individual que supera las expectativas. ¡Ustedes molan! Sigan con el buen trabajo. Gracias de nuevo.
Gracias. Creo que su empresa hace que sea muy sencillo tomar la muestra y enviarla. Incluso un campesino sureño puede hacerlo siguiendo sus instrucciones. Hice que Doug Hall de Wayest Safety se capacitara sobre cómo extraer las muestras por primera vez. Él te recomendó mucho y eso fue lo suficientemente bueno para mí. Su empresa me demostró su valía muy rápidamente con su rápida respuesta. La Sra. Lindsey con su empresa fue de gran ayuda para mí.
Sí, ya hemos recibido nuestro informe, gracias. Esta es la segunda vez que trabajamos con su empresa … y estamos muy contentos con la calidad de su servicio al cliente en ambas ocasiones. No tuvimos ningún problema con el uso del AirCheck Kit y recibimos los resultados de manera muy oportuna. Recomendaría su empresa a cualquiera que me pregunte. Gracias nuevamente por toda su ayuda y espero trabajar con usted en el futuro.
LLAME GRATIS
1.800.247.1024
LÍNEA LOCAL
512.263.0000
HORARIO DE OFICINA (CT)